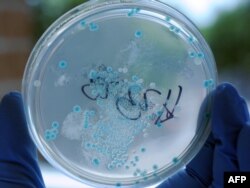
Колония кишечной палочки в чашечке Петри

В 2008 году экипаж вертолета ВВС Венесуэлы, патрулировавшего район в верховьях реки Ориноко, неподалеку от границы с Бразилией, случайно обнаружил скрытую под зеленым покровом джунглей небольшую деревушку. Обширные леса в этой местности населяют охотники-собиратели из группы индейских племен яномамо – это одно из немногих оставшихся мест на Земле, где еще можно встретить людей, ни разу не сталкивавшихся с цивилизацией. Название обнаруженной военными деревни и ее точные координаты держатся в секрете до сих пор – правительство Венесуэлы таким образом старается оградить жителей от любопытства туристов. Но ученые вошли в контакт с индейцами: в 2009 году в деревне побывала медицинская миссия.
В поселении на тот момент проживали всего 54 человека, добывавших пропитание охотой и собирательством. Земледелие и скотоводство индейцы не практиковали, их диета состояла из диких бананов и другой растительной пищи, а также мелких млекопитающих, крабов, лягушек и пресноводной рыбы. Аборигены вели торговлю с соседними племенами, пользовались мачете и даже знали от более цивилизованных сородичей слово medicina, однако ближайший медпункт находился от деревни в двух неделях пути. Индейцы утверждали, что никогда не принимали лекарств и не употребляли в пищу ничего, что нельзя было бы поймать или собрать в окрестных джунглях. Медики с удивлением отметили, что жители деревни практически здоровы. Они страдают от множества паразитов, но не болеют диабетом, аутоиммунными и сердечно-сосудистыми заболеваниями. Исследователи взяли у 34 жителей деревни образцы слюны, кожи и фекалий и только после этого дали антибиотики нескольким детям, которых беспокоил кашель.
Взятые анализы были обработаны в Медицинской школе университета Нью-Йорка только три года спустя. Основной целью ученых было изучить микрофлору аборигенов. Можно было ожидать, что она окажется намного богаче, чем у представителей западного мира, ведь хорошие гигиенические условия и антибактериальные лекарства постепенно привели к тому, что у людей, живущих в цивилизации, некоторые бактерии исчезли вообще, а число других значительно сократилось. И действительно: такого бактериального многообразия, как у яномамо, исследователи не встречали ни у жителей западных стран, ни даже у представителей других архаических народов, совсем недавно вошедших в контакт с цивилизацией.
Но главный сюрприз был не в этом. Если жители деревни наблюдали пролетающий над ними армейский вертолет с копьями и луками в руках, то живущие в них бактерии оказались почти так же хорошо вооружены против современных антибиотиков, как и микробы западного мира. И это невероятный факт, ведь бактерии приобретают устойчивость к антибиотикам в процессе гонки вооружений, которую фармацевты ведут в пробирках, а микробы – в организмах пациентов. Резистентные к антибиотикам бактерии – мутанты, выжившие в битве против лекарств. Откуда же взялась устойчивость у микробов, никогда не сталкивавшихся с западной медициной?
Миру грозит постантибиотическая эра, когда люди будут снова умирать от самых обычных болезней и травм, потому что многие инфекции окажутся непобедимыми
Доклад Всемирной организации здравоохранения, опубликованный в 2014 году, был посвящен новой глобальной угрозе человечеству: "Миру грозит постантибиотическая эра, когда люди будут снова умирать от самых обычных болезней и травм, потому что многие инфекции окажутся непобедимыми". Фактически мы проигрываем борьбу с микробами: за 70 лет использования антибиотиков погибли миллионы поколений бактерий – но только чтобы дать своим потомкам умение противостоять лекарствам. А вот создание новых поколений антибиотиков не успевает за эволюцией патогенов по разным причинам, в том числе и, как ни печально, чисто экономическим – подробнее об этом можно прочесть в большом материале Радио Свобода.
В этом свете особенно важно глубоко разобраться в многообразии механизмов, которые позволяют бактериям вырабатывать устойчивость к антибиотикам. Как микробы учатся противостоять лекарствам?
Вообще говоря, микробы – такие же живые организмы, как и люди, только состоящие всего из одной клетки. Антибиотики – яды, которые нарушают какие-то происходящие в клетке процессы, например, синтез клеточной стенки или производство главных участников внутриклеточной машинерии – ферментов и белков. Соответственно, бактерии нужно бороться либо с самим ядом, либо с последствиями его действия. “Например, может появиться вариант нарушаемого антибиотиком фермента, который устойчив к этому действию, – объясняет Андрей Летаров, заведующий лабораторией вирусов микроорганизмов Института микробиологии имени С.Н. Виноградского. – Либо появляется новый фермент, который эффективно разрушает или во всяком случае делает безопасным для клетки сам антибиотик. Наконец, может запуститься система эффективного откачивания антибиотика из клетки”.
Большинство из таких защитных систем не могут вдруг начать работать в клетке, например, новые белки, на которые не действует антибиотик, должны быть закодированы новыми последовательностями генов. Устойчивость к антибиотикам – коллективное достижение, ее приобретают не отдельные бактерии, а целые популяции.
“У бактерий большие популяции и селекция с антибиотиками довольно жесткая – то есть те клетки, у которых есть какая-то степень устойчивости, получают довольно большие преимущества, – рассказывает Летаров, – и поэтому соответствующие мутации отбираются довольно быстро”.
Такой естественный отбор происходит тем скорее, чем больше популяция бактерий и чем чаще ее подвергают воздействию антибиотиков. Идеальная среда для этого процесса – больничная палата, и именно поэтому первыми обрели угрожающую устойчивость к практически всем классам антибиотиков так называемые “больничные инфекции”, например, тяжелые пневмонии, вызываемые золотистыми стафилококками.
Однако бактерии, найденные в биологических образцах индейцев яномамо, скорее всего, никогда не сталкивались с синтезированными людьми токсинами – как сами индейцы не сталкивались с таблетками и шприцами. Разумеется, и эти микробы эволюционировали, но факторы селекции определялись не антибиотиками. Откуда же взялась устойчивость?
Точного ответа пока ни у кого нет. Андрей Летаров предлагает несколько гипотез, самая удивительная из которых заключается в том, что бактерии могли учиться бороться с собственными генами, а в итоге приобрели умение противостоять современному классу антибиотиков.
“Есть гены, – рассказывает Летаров, – которые можно отнести к классу “эгоистичной ДНК”. Они, по-видимому, рассматривают бактерии как среду обитания, с которой их интересы могут совпадать, а могут и не совпадать. Эти гены не хотят, чтобы клетка могла от них легко избавиться, поэтому они иногда кодируют так называемые модули привыкания, представляющие собой комбинацию из токсина и антитоксина, то есть яда и противоядия. При этом противоядие значительно менее стабильно, чем яд. Если в клетке такой генетический элемент теряется, то противоядие деактивируется значительно быстрее, и клетка рискует погибнуть под действием яда”.
На эти гены можно смотреть как на паразитов, но Андрей Летаров отмечает, что микробная эволюция идет уже 3,5 миллиарда лет, “за этот срок четкая граница в отношениях "паразит – хозяин" стерлась”. За миллиарды лет клетки научились использовать эгоистичные гены в своих целях (такие механизмы известны), но последние продолжают травить хозяина и одновременно капать противоядие. Несмотря на относительную пользу, которую приносит паразитический участок ДНК, бактерии были бы рады избавиться от неприятных пассажиров. И на помощь им приходит, разумеется, эволюция.
“У бактерий есть не очень сильная, но постоянно действующая селекция: найти гиразу, фермент, на который действует модуль привыкания, которая была бы устойчивой к токсину, – рассказывает Летаров. – Обычно клетки, потерявшие эгоистичный модуль, помирают, но все-таки не все, некоторые учатся бороться с токсином, мутируют и учатся блокировать яд. Не иметь паразитический модуль – небольшое, но все же преимущество, поэтому такие варианты бактерий накапливаются в популяции”.
Замечательное совпадение заключается в том, что ровно на тот же фермент, на который воздействуют токсины паразитического модуля, влияют антибиотики из популярной современной группы фторхинолонов. “Оказывается, что некоторые из таких мутантов, сумевших избавиться от паразитического модуля, устойчивы еще и к фторхинолонам, – говорит Летаров. – Обычно их не очень много, потому что селективное преимущество не очень велико, но они появляются сами по себе, безо всякой западной медицины”.
Конечно, это достаточно экзотическая гипотеза, и она вряд ли может объяснить весь комплекс резистентности к антибиотикам, обнаруженной в венесуэльских бактериях. Возможны и другие, более простые объяснения. Например, устойчивость могла выработаться в микробах в ответ на природные антибиотики, которые находятся в окружающей среде (что, впрочем, не объясняет устойчивость к искусственно созданным токсинам, которая также была обнаружена). Вот еще одно предположение: мы наблюдаем побочный продукт эволюции самих белков, на которые обычно нацелено действие антибиотиков. Естественный отбор мог быть вызван другими факторами, а устойчивость к лекарствам – почти случайный сопутствующий эффект.
Сами авторы исследования пока тоже теряются в догадках. Может быть, в природе есть яды, чрезвычайно похожие на современные антибиотики, но пока не обнаруженные учеными? А может, в составляющих человеческую микрофлору бактериях есть общий механизм выявления особенностей, присущих всем антибиотикам, и уже известным человечеству и тем, что мы сможем разработать в будущем?
Сделанное в джунглях удивительное биологическое открытие поможет пролить свет на то, как опасные патогены учатся противостоять лекарствам – даже если они с этими лекарствами никогда не сталкивались. Учитывая, что через несколько десятков лет мы можем оказаться бессильны перед самой обыкновенной кишечной палочкой, будущее благополучие или даже выживание человечества очень сильно зависит от этой работы.